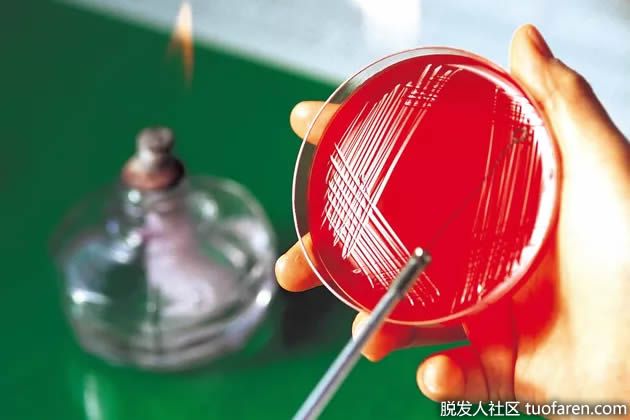
【圖】益生菌過量

數以百萬計的細菌、真菌和其他微生物在你的身體裏安家。雖然細菌會引起感染和疾病,但有些細菌是無害的,甚至是有益的。有益的細菌,被稱為益生菌,可以幫助你的免疫系統,促進整體健康。雖然服用益生菌補充劑沒有過量的風險,但它可能會造成有害的副作用。在服用益生菌之前,請諮詢醫生,以確保您服用的劑量安全、適當。
益生菌的功能
幾種細菌在人體中具有有益作用,包括嗜酸乳桿菌,保加利亞乳桿菌,兩歧雙歧桿菌,嗜熱鏈球菌和乾酪乳桿菌GG。根據馬里蘭大學醫學中心的説法,益生菌可以有效地治療陰道感染,改善乳糖不耐症症狀並治療胃腸道問題,例如腹瀉和消化不良。但是,需要更多的科學證據來支持在這些情況下使用益生菌。
劑量
你可以通過某些食物或補品將益生菌加入到你的飲食中。味噌、豆豉、某些類型的酸奶和富含益生菌的奶製品。益生菌補充劑有塗層膠囊、凍幹顆粒、粉末和液體形式。一般來説,一劑益生菌的菌落形成單位為10億到100億。一些醫學專業人士會根據某些疾病開出更大的劑量,所以要諮詢醫生,瞭解更多關於適合你的劑量的信息。
過量
服用過多的藥物通常對你的健康有害。根據勞森健康研究所的格雷戈爾·裏德的研究,雖然在理論上可能會過量使用益生菌,但目前還沒有過量使用益生菌的記錄。如果你服用了過多的益生菌補充劑,你的身體會通過糞便排出多餘的細菌。然而,服用過多的益生菌補充劑可能會導致不舒服的副作用。
副作用
服用益生菌最常見的副作用是胃腸道問題,如噁心、腹瀉、脹氣或腹脹。根據馬里蘭大學醫學中心的研究,免疫系統受損或人工心臟瓣膜的人在服用益生菌時,感染細菌的風險增加。益生菌補充劑的另一個風險是,細菌可能與藥物相互作用,因此與醫生討論您的補充使用益生菌。






































